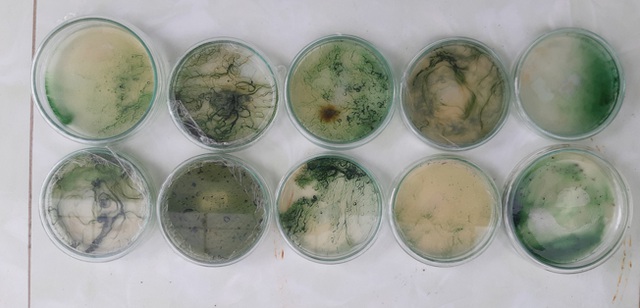

Tảo xoắn Spirulina: Siêu thực phẩm của thế kỷ 21
Vi tảo là một loại thực phẩm chức năng đã và đang nhận được sự quan tâm, tin dùng của người Việt, bởi vô số những tác dụng thần kỳ với sức khỏe, được chứng minh bởi các nghiên cứu khoa học, cũng như kết quả thực tế mang lại cho người dùng.

Tảo xoắn Spirulina được coi là siêu thực phẩm của thế kỷ 21
Trong số các loại vi tảo thì tảo xoắn Spirulina được nuôi quy mô lớn sớm nhất và hiện cũng là chủng vi tảo thương phẩm phổ biến nhất. Sở hữu những con số cực kỳ ấn tượng về giá trị dinh dinh dưỡng cùng nhiều đặc tính ưu việt, tảo xoắn Spirulina đã được Tổ chức Y tế Thế giới (WHO) công nhận là “Thực phẩm bảo vệ sức khỏe tốt nhất của loài người trong thế kỷ 21”.
Hiểu nhầm phổ biến về tảo xoắn Spirulina platensis!
Trái ngược với suy nghĩ của nhiều người rằng, tảo xoắn Spirulina có 80smusiclyrics gốc từ Nhật Bản hay đây là nơi có nguồn nguyên liệu dồi dào và chất lượng cao nhất, bởi tuyệt đại đa số các sản phẩm tảo Spirulina có mặt ở thị trường Việt Nam hiện nay đều có xuất xứ từ đất nước mặt trời mọc, trên thực tế, nguồn gốc của các chủng giống tảo xoắn lại từ Cộng hòa Chad (Châu phi) hoặc Mexico.

Hình ảnh tảo xoắn Spirulina platensis dưới kính hiển vi
Bên cạnh đó vì là loài ưa ánh sáng và nhiệt độ cao, nên tảo xoắn Spirulina phát triển tốt và cũng được nuôi chủ yếu ở các nước Nhiệt Đới. Các nước Ôn Đới và Hàn Đới hầu như không nuôi loại tảo này.
Tiềm năng phát triển của ngành sản xuất vi tảo tại Việt Nam
Với điều kiện khí hậu đặc trung của khu vực Nhiệt Đới: thời gian chiếu sáng và nhiệt độ trung bình năm cao, trên thực tế, Việt Nam là một đất nước có tiềm năng rất lớn để phát triển tảo xoắn. Nếu được quan tâm đầu tư đúng mức về mặt công nghệ cũng như nghiên cứu chuyên sâu, sản phẩm tảo xoắn, nói rộng ra là nhiều loại vi tảo có ích khác “Made in Vietnam”, sẽ có chất lượng không hề thua kém các nước tiên tiến.
Theo đuổi mục tiêu này, Phó giáo sư, tiến sĩ Nguyễn Đức Bách, trưởng khoa Công Nghệ Sinh học, Học viện Nông nghiệp Việt Nam, cùng các cộng sự của mình dã nỗ lực đẩy mạnh nghiên cứu, phát triển lĩnh vực Công nghệ sinh học vi tảo, qua nhiều năm nỗ lực, nhóm nghiên cứu đã đạt được nhiều kết quả tích cực, trong đó phải kể đến việc thành lập được “Trung tâm nghiên cứu và Phát triển Công nghệ sinh học vi tảo”, với nhiệm vụ trọng tâm là phân lập, làm thuần, lưu giữ ngân hàng chủng giống vi tảo và phát triển các quy trình nuôi tảo ở quy mô lớn.

PGS.TS Nguyễn Đức Bách (thứ 2 từ phải sang) và Thạc sĩ Phí Thị Cẩm Miện (thứ 3 từ phải sang), những nhà khoa học Việt đang theo đuổi mục tiêu phát triển lĩnh vực Công nghệ sinh học vi tảo.
Với hướng tiếp cận sản xuất sinh khối ở quy mô công nghiệp, PGS.TS Nguyễn Đức Bách và cộng sự đã xây dựng các mô hình và kỹ thuật nuôi nhiều loài vi tảo quan trọng, điển hình như tảo xoắn Spirulina và Chlorella.

Trung tâm nghiên cứu và Phát triển Công nghệ sinh học vi tảo thuộc khoa Công nghệ sinh học, Học viện Nông nghiệp Việt Nam.
Trao đối với PV Dân Trí, PGS.TS Nguyễn Đức Bách cho biết: “Các loại vi tảo có tiềm năng rất lớn trong lĩnh vực thực phẩm chức năng, dược phẩm, sản phẩm làm đẹp và thậm chí là cả chăn nuôi. Đơn cử như tảo xoắn Spirulina platensis, cũng là loại vi tảo được Trung tâm phát triển sớm nhất, sở hữu những giá trị dinh dưỡng mà khó có loại thực phẩm nào hiện nay có thể bì kịp. Cụ thể, Spirulina platensis có hàm lượng Canxi cao gấp 1,5 lần sữa, hàm lượng β-carotene cao gấp 15 lần cà rốt, hàm lượng sắt cao gấp 25 rau chân vịt, đặc biệt protein của tảo xoắn chiếm trên dưới 75%, cao gấp 5 lần thịt bò và đứng đầu trong các loại thực phẩm.”
Bên cạnh giá trị sử dụng cực kỳ cao, vi tảo cũng là lời giải “hoàn hảo” cho thực trạng quỹ đất ngày càng hạn hẹn, khí hậu diễn biến thất thường, các nguồn tài nguyên thiên nhiên dần cạn kiệt, vốn đang là những thách thức cực kỳ lớn với các sản phẩm nông nghiệp truyền thống, đe dọa đến an ninh lượng thực toàn cầu!
Vi tảo được nhân giống và sản xuất như thế nào?
Theo chia sẻ của Thạc sĩ Phí Thị Cẩm Miện, cán bộ quản lý trực tiếp các quy trình nuôi tảo tại Trung tâm Nghiên cứu và Phát triển Công nghệ sinh học Vi tảo, các chủng giống vi tảo sau khi được phân lập và thu thập từ nhiều nguồn khác nhau sẽ được đánh giá khả năng sinh trưởng, thích ứng với các điều kiện thời tiết, mùa vụ và phân tích giá trị dinh dưỡng.

Các chủng giống tảo đang được nuôi ở quy mô phòng thí nghiệm.
Các chủng vi tảo ưu tú có giá trị dinh dưỡng, tiềm năng ứng dụng cao sẽ được sử dụng để nuôi ở quy mô lớn. Các công đoạn nuôi tảo được thực hiện từng cấp theo các quy mô khác nhau, trước tiên trong các bình nuôi nhỏ trong phòng thí nghiệm, tiếp đó nuôi trong các hệ thống lớn hơn. Ở quy mô sản xuất, tảo giống được nhân trong các hệ thống Photobioreactor đặt ngoài trời hoặc trong nhà lưới.

Hệ thống nhân giống khép kín Photobioreactor
Qua nhiều nghiên cứu và thử nghiệm, Trung tâm đã phát triển được chủng tảo xoắn Spirulina (VNUA03) được đưa vào danh mục của Bộ Nông nghiệp và Phát triển Nông thôn. Đây cũng là chủng giống tảo xoắn Spirulina đầu tiên được công nhận và đưa vào sản xuất ở quy mô lớn.
“Hiện tại, Trung tâm đang tiến hành nhân giống vi tảo bằng hệ thống khép kín Photobioreactor, đây là hệ thống nhân giống kín tiên tiến được lắp đặt theo dạng modul, mỗi modul là tập hợp các ống thủy tinh trong suốt với đường kính từ 70-100 mm (tùy cấp độ nhân giống) được kết nối liền mạch với nhau và với bể chứa. Tham gia vào modul còn có một bơm tăng áp để tạo thành dòng nước tuần hoàn. Ở điều kiện thực tế của Trung tâm, mỗi modul nhỏ có thể tích sử dụng khoảng 300 lít và con số này sẽ gấp đôi với modul lớn” – Thạc sỹ Miện nói.

Môi trường nuôi vi tảo trong hệ thống Photobioreactor luôn được tuần hoàn nhờ máy bơm tăng áp.
Ngoài hệ thống nhân giống khép kín, Trung tâm Nghiên cứu và Phát triển Công nghệ sinh học Vi tảo hiện sử dụng các bể nuôi Raceway lên tới 100 m3 để thử nghiệm các quy trình nuôi tảo ở quy mô lớn, đồng thời phục vụ cho công tác đánh giá khả năng phát triển thực tế của chủng giống, cũng như hỗ trợ các giải pháp để hoàn thiện công nghệ nuôi vi tảo.


Hệ thống nhân sinh khối Raceway với các cánh quạt cỡ lớn đóng nhiệm vụ đảm bảo sự tuần hoàn của môi trường nước nuôi.
Về những điều kiện khắt khe trong công nghệ nuôi vi tảo, thạc sỹ Phí Thị Cẩm Miện nhấn mạnh: “Để có thể đảm bảo nguồn giống vi tảo thành phẩm có chất lượng cao: thuần chủng 100%, không có tạp nhiễm, sức sống tốt và đặc biệt là an toàn tuyệt đối với con người nếu sử dụng trực tiếp, nguồn nước được sử dụng làm môi trường nuôi tảo bắt buộc phải được lọc qua nhiều cấp và khử khuẩn. Bên cạnh đó, các thành phần dinh dưỡng để nuôi vi tảo cũng đòi hỏi đạt mức độ tinh khiết phân tích hoặc tiêu chuẩn dùng trong thực phẩm!”.
Cũng qua tìm hiểu, chúng tôi được biết, bên cạnh ngân hàng các chủng giống Spirulina, Trung tâm Nghiên cứu và Phát triển Công nghệ sinh học Vi tảo còn đang lưu giữ hơn 50 loài vi tảo với hàng trăm chủng giống khác nhau phục vụ cho nghiên cứu cơ bản và ứng dụng.
Nguồn: https://dantri.com.vn/khoa-hoc-cong-nghe/vi-tao-made-in-vietnam-muc-so-thi-cong-nghe-nuoi-tao-spirulina-cua-cac-nha-khoa-hoc-viet-20190929214108005.htm
———————————————————-
Mọi thông tin chi tiết vui lòng liên hệ:
VNUA Pharma – Tinh Hoa Giá Trị Việt
Hotline/Zalo: 0906393003
Website: https://kisbone.efy.vn/
Gmail: vnuapharma.official@gmail.com
Fanpage: https://www.facebook.com/vnuapharma.vn
Group: https://www.facebook.com/groups/vnuapharma.vn
Youtube:https://www.youtube.com/vnuapharma.vn
.jpg)